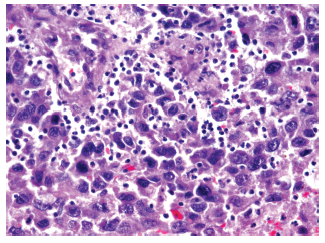

Volume: 16 Issue: 1 March 2018 - Supplement - 1
FULL TEXT
Objectives: Hepatocellular carcinoma is the predominant malignancy in patients with cirrhosis and chronic liver disease. Our aim was to assess the morphologic, radiologic, and immunologic characteristics of hepatocellular carcinoma and liver cirrhosis concerning surgical treatment tactics.
Materials and Methods: We performed a cross-sectional analysis of a prospective study performed at the JSC National Scientific Center of Surgery (named after A. Syzganov). The study included 58 patients: 31 with hepatocellular carcinoma (53.4%) and 27 with chronic liver disease (46.6%). The average age of patients was 55.6 ± 1.7 years.
Results: Patients were tested for hepatitis B virus and hepatitis C virus infection. Patients with elevated levels of alfa-fetoprotein, alanine aminotransferase, and total bilirubin were detected. Morphologic signs of hepatocellular carcinoma with a predominance of a trabecular type rather than a solid type of tumor were found. Patients with hepatocellular carcinoma underwent surgical liver resection and transarterial chemoembolization before living-donor liver transplant. One-year survival rate of patients with hepatocellular carcinoma was 93.5%.
Conclusions: The diagnosis and surgical options for hepatocellular carcinoma should be studied, taking into account the expanded laboratory characteristics of cancer.
Key words : Cirrhosis, Liver disease, Liver transplant
Introduction
In Asia and Africa, which have the greatest prevalence of hepatitis infection, the incidence of hepatocellular carcinoma (HCC) is 120 per 100 000.1 Those with a combination of risk factors, chronic hepatitis B virus (HBV), and cirrhosis have a 100-fold increased risk of HCC. Approximately 5% to 30% of patients with hepatitis C virus (HCV) will have chronic liver disease, and 30% will have cirrhosis and HCC.2,3 In Kazakhstan, diagnostic and treatment issues have remained focussed on liver tumors,4 due to the complexity of early diagnosis, chemotherapy's lack of effectiveness, the primary diseases underlying cirrhosis, and the complexity of choosing treatment options with invasive methods.5
In this study, our objective was to assess the morphologic, radiologic, and immunologic characteristics of HCC and liver cirrhosis with regard to surgical treatment options.
Materials and Methods
We conducted a cross-sectional analysis of a prospective study that included patients with HCC and chronic liver disease who had been treated in the Department of Hepatopancreatic Surgery from 2015 to 2017. Of 58 patients treated, 31 had HCC (53.4%) and 27 had other chronic liver diseases (46.6%). Our total patient group included 30 women (51.7%) and 28 men (48.3%) with an average age of 55.6 ± 1.7 years. The 31 patients with HCC ranged in age from 34 to 70 years (60.2 ± 1.5; 61.3% men and 38.7% women) (Table 1).
All patients had laboratory tests for alfa-fetoprotein (AFP), total bilirubin, nondirect bilirubin, alanine aminotransferase (ALT), and aspartate aminotransferase (AST). Patients also had immunologic assays for HBV and HCV, histologic analyses of liver tissue, and computed tomographic (CT) scans.
Treatment strategies for HCC with or without liver cirrhosis were determined according to the Barcelona clinic liver cancer (BCLC) staging of HCC and with application of the Milan criteria. Data were collected prospectively in our institutional HCC registry.
The study protocol was approved by our Institutional Local Research Ethics Committee (June 26, 2016), and the study protocol conformed with the ethical standards of the Declaration of Helsinki. All participants in the study submitted informed consent.
All analyses were conducted with SPSS software (SPSS: An IBM Company, version 18.0, IBM Corporation, Armonk, NY, USA) and MedCalc. We used t tests and chi-square tests, with a relative P < .05 used to determine significance. Continuous data are presented as mean and standard deviation or median, and categorical data are presented as frequency. Comparisons of patient characteristics and outcomes were conducted in the 2 patient groups (those with HCC and those with chronic liver disease).
Results
The study group included 14 patients with HCC and liver cirrhosis (45.2%) (Figure 1) and 17 patients with HCC without liver cirrhosis (54.8%) (Figure 2). The control group (patients with chronic liver disease) included 12 patients with liver fibrosis (44.5%), 7 patients with primary biliary cirrhosis (25.9%), 3 patients with autoimmune hepatitis (11.1%), and 5 patients with cirrhosis due to other causes (18.5%).
In patients with HCC, enzyme-linked immunosorbent assay detected antibodies with titer positive to HBV in 14 patients (45.2%) and titer positive to HCV in 10 patients (32.3%), of whom 1 patient (3.2%) had positive results for both HBV and HCV; in addition, 7 patients (22.6%) were HBV/HCV negative. In patients with chronic liver disease, 4 patients (14.8%) showed antibodies with titer positive for HBV (14.8%) and 4 patients (14.8%) tested positive for HCV (Table 2).
Morphologic data were characterized for signs of HCC. Trabecular-type HCC was predominant, shown in 26 patients (83.9%),versus solid tumor type, shown in 5 patients (16.1%). Degree of malignancy according to the Edmondson-Steiner system showed 8 patients (25.8%) having grade I, 10 patients (32.3%) having grade II, 9 patients (29.0%) having grade III, and 4 patients (12.9%) having grade IV (Figures 3-6 show resection of archived materials).
Surgical treatment
In the 14 patients (45.2%) with clinical signs of HCC and liver cirrhosis (AFP
of 35.5 ± 11.3 U/mL, ALT of 80.6 ± 11.9 U/mL, and total bilirubin of 26.2 ± 5.2
μmol/L), transarterial chemoembolization (TACE) was performed. Living-donor
liver transplant was performed in 9 patients (29.0%) with HСС according to the
BCLC stage (0-1) and cirrhosis score (Child-Pugh A or A/B) after TACE
procedures.
In the 17 patients (54.8%) with HCC without cirrhosis (AFP of 5.21 ± 1.7 U/mL, ALT of 46.5 ± 26.7 U/mL, and total bilirubin of 17.8 ± 4.5 μmol/L), liver resection and TACE were performed. Eight patients (25.8%) had partial liver resection by laparotomy or a mini laparotomy approach, with 3 of these patients (9.7%) having liver resection as a second-stage treatment after TACE.
In total, 26 patients (83.9%) with HCC had TACE repeatedly at intervals of 4 to 6 months, at 5 times for 1 patient (3.2%), 4 times for 1 patient (3.2%), 3 times for 2 patients (6.5%), 2 times for 4 patients (12.9%), and 1 time for 18 patients (58.1%).
Among the control group patients with chronic liver disease, 4 patients (14.8%) underwent liver transplant, of whom 2 (7.4%) received livers from living donors and 2 (7.4%) received livers from deceased donors. In addition, 8 patients (29.6%) underwent selective chemoembolization and 15 patients (55.6%) are continuing to receive conservative therapy.
One-year survival rate was 93.5%. In patients with HCC, 2 patients (6.5%) died less than 1 year after repeated TACE.
Discussion
Surgical options for patients with HCC with and without liver cirrhosis depend on the pathologic and morphologic characteristics. Options (liver transplant, resection, ablation, and TACE) should depend on the stage of liver cirrhosis and the size of tumor according to the Milan criteria.6,7
According to the literature, liver resection to obtain R0 (tumor-free marginal resection) provides a 3-year survival of 54% in patients with HCC and noncirrhotic liver. Liver transplant can offer better long-term survival for patients with HCC and cirrhosis because it offers the possibility to treat the tumor and the main disease, although use of liver transplant to treat HCC is controversial.7-9 Patients with a single node smaller than 5 cm or 3 nodes smaller than 3 cm who are not suitable for resection are encouraged to have liver transplant. When these Milan criteria guidelines are followed, patients have a 5-year survival rate and a disease-free overall survival rate of more than 65%.7,10 In cases when recipients have waited for a donor for a long time (more than 6 months), they are encouraged to undergo resection, local ablation, or TACE to avoid tumor progression risk and to offer a bridge to transplant.11
Transarterial chemoembolization for HCC with cirrhosis, or palliative care, are generally accepted standard treatments as "bridge" options when waiting for transplant.12,13 Transarterial chemoembolization is recommended for patients for HCC and BCLC B stage without vascular invasion and extrahepatic metastases and multinodal asymptomatic HCC.13,14
Conclusions
The diagnosis and determination of the strategy for surgical treatment of HCC should be further studied, taking into account the expanded laboratory characteristics of cancer.
References:
- Parkin DM, Bray F, Ferlay J, Pisani P. Global cancer statistics, 2002. CA Cancer J Clin. 2005;55(2):74-108.
CrossRef - PubMed - Oh JK, Shin HR, Lim MK, et al. Multiplicative synergistic risk of hepatocellular carcinoma development among hepatitis B and C co-infected subjects in HBV endemic area: a community-based cohort study. BMC Cancer. 2012;12:452.
CrossRef - PubMed - Chen CJ, Yang HI, Su J, et al. Risk of hepatocellular carcinoma across a biological gradient of serum hepatitis B virus DNA level. JAMA. 2006;295(1):65-73.
CrossRef - PubMed - Aliev MA, Sultanaliev TA, Seisembaev MA, et al. [The diagnosis and surgical treatment of cavernous hemangiomas of the liver]. Vestn Khir Im I I Grek. 1997;156(4):12-16.
PubMed - Huang TS, Shyu YC, Turner R, Chen HY, Chen PJ. Diagnostic performance of alpha-fetoprotein, lens culinaris agglutinin-reactive alpha-fetoprotein, des-gamma carboxyprothrombin, and glypican-3 for the detection of hepatocellular carcinoma: a systematic review and meta-analysis protocol. Syst Rev. 2013;2:37.
CrossRef - PubMed - Benevento B, Santoriello A, Perna G, et al. Efficacy of percutaneous radiofrequency ablation (RFA) for hepatocellular carcinoma in elderly patients. BMC Geriatrics. 2011;11(Suppl 1):A45.
CrossRef - Sotiropoulos GC, Molmenti EP, Lang H. Liver transplantation for hepatocellular carcinoma in the MELD era: leading roles of MELD score, AFP level, and recipient age as predictors of survival. Dig Dis Sci. 2009;54(4):917.
CrossRef - PubMed - Baimakhanov B, Chormanov A. Hepatic allograft salvage in LDLT after early HAT by combined surgical and angiographic techniques. Transplant Int. 2015;28:344.
- Choti MA. Transplantation versus resection for hepatocellular carcinoma in the mild cirrhotic: framing the debate. J Gastrointest Surg. 2009;13(6):1021-1022.
CrossRef - PubMed - Baimakhanov BB, Chormanov AT. Surgical treatment of complications after related liver transplantation in the city clinical hospital N7 (correction of complications). Transplant Int. 2015;28:334.
- Salgia RJ, Goodrich NP, Marrero JA, Volk ML. Donor factors similarly impact survival outcome after liver transplantation in hepatocellular carcinoma and non-hepatocellular carcinoma patients. Dig Dis Sci. 2014;59(1):214-219.
CrossRef - PubMed - Scartozzi M, Baroni GS, Faloppi L, et al. Trans-arterial chemo-embolization (TACE), with either lipiodol (traditional TACE) or drug-eluting microspheres (precision TACE, pTACE) in the treatment of hepatocellular carcinoma: efficacy and safety results from a large mono-institutional analysis. J Exp Clin Cancer Res. 2010;29:164.
CrossRef - PubMed - Satake M, Uchida H, Arai Y, et al. Transcatheter arterial chemoembolization (TACE) with lipiodol to treat hepatocellular carcinoma: survey results from the TACE study group of Japan. Cardiovasc Intervent Radiol. 2008;31(4):756-761.
CrossRef - PubMed - Li J, Dong Z, Zhang X,Huang C, Xu J. Transcatheter arterial chemoembolization in combination with stereotactic body radiation therapy in primary liver carcinoma: a systematic review and meta-analysis. Int J Clin Exp Med. 2017;10(2):1816-1827.

Volume : 16
Issue : 1
Pages : 140 - 144
DOI : 10.6002/ect.TOND-TDTD2017.P32
From the JSC "National Scientific Center of Surgery," Almaty, Kazakhstan
Acknowledgements: The research was carried out as part of the scientific program
"Innova Health Technologies to Improve the Results of Treatment of Chronic
Diseases and Consequences of Injuries With Severe Loss of Function and Severe
Complications." The Budget Administrator is the Ministry of Health Republic of
Kazakhstan. The authors have no conflicts of interest to declare.
Corresponding author: Gulziya Ismailova, Science Department, JSC "National
scientific center of surgery," Zheltoksan str. 62, 050004 Almaty, Kazakhstan
Phone: +77 01 822 81 88
E-mail: dr.ismailova@mail.ru

Figure 1. Hepatocellular Carcinoma and Liver Cirrhosis

Figure 2. Hepatocellular Carcinoma

Figure 3. Hepatocellular Carcinoma, Showing Adenoma-Like Variant With Marked Fibrosis Fields (6 points) (hematoxylin and eosin staining; ×200)

Figure 4. Hepatocellular Carcinoma Showing Trabecular Structure With Areas of Proliferation and Coarse Connective Tissue Fibers (hematoxylin and eosin staining; ×200)

Figure 5. Hepatocellular Carcinoma Showing Sites of Extensive Hemorrhage and Foci of Tumor Necrosis (hematoxylin and eosin staining; ×200)

Figure 6. Hepatocellular Carcinoma With Presence of Large Hyperchromic, Atypical Nuclei With Pronounced Amount Mitosis (hematoxylin and eosin staining; ×200)

Table 1. Main Features of Participants
Table 2. Clinical Characteristics